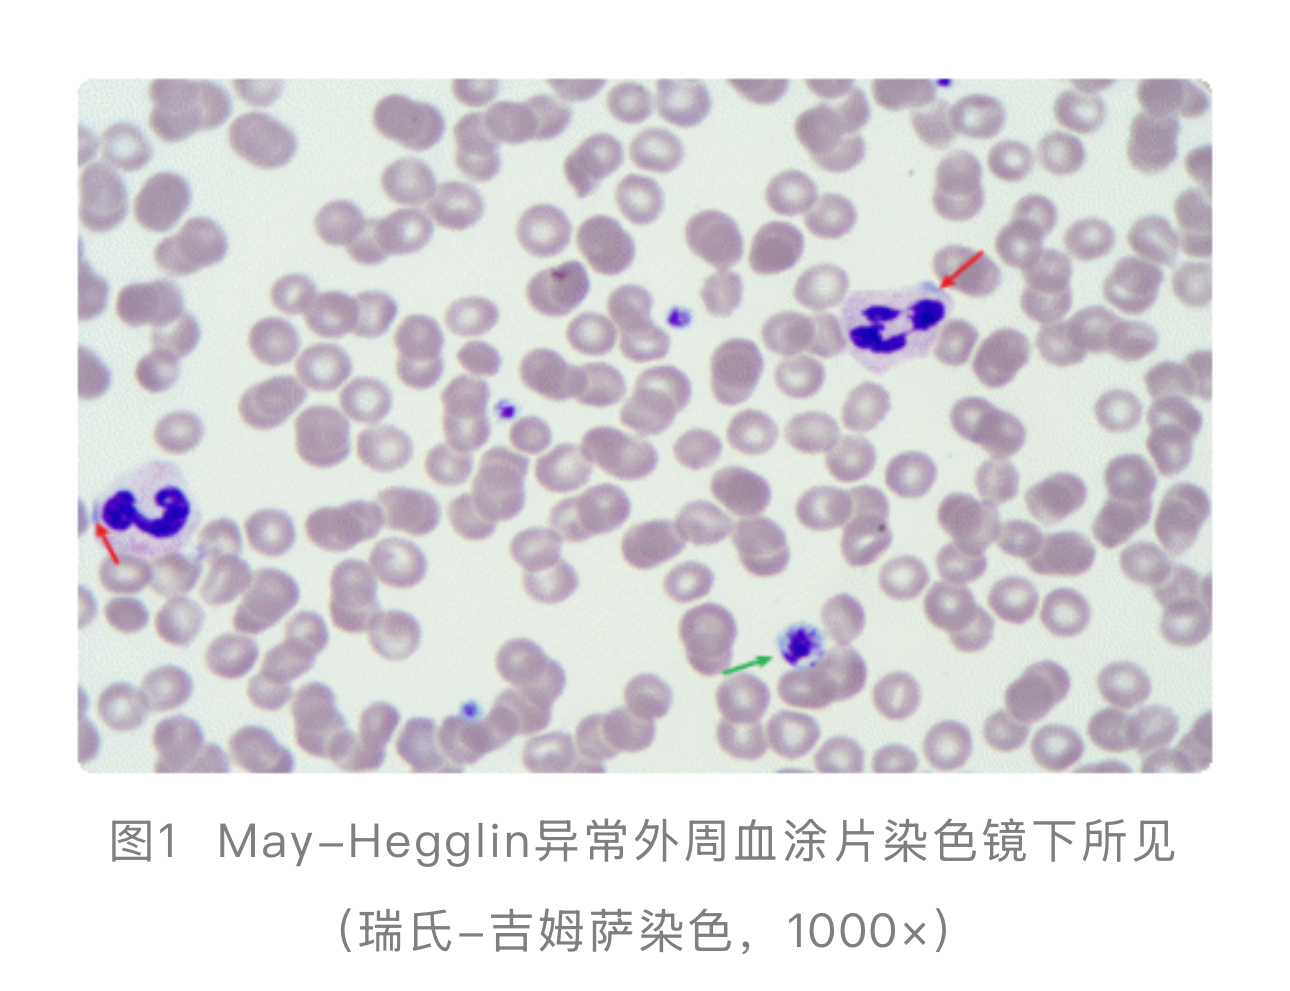
1775031879460515.jpg
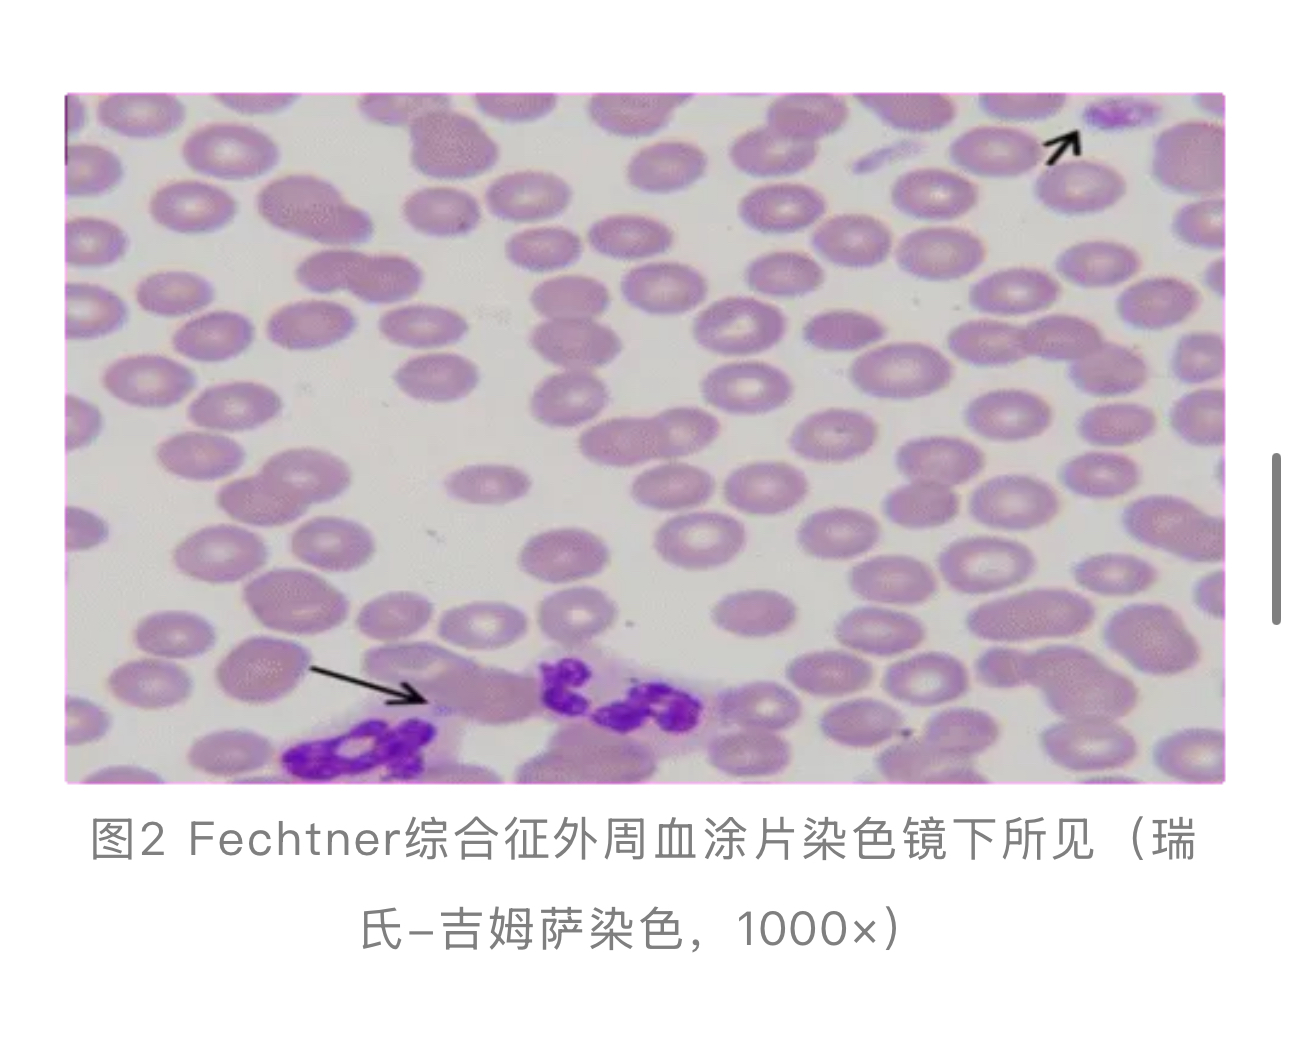
1775031891596457.jpg

手握“钥匙”,解锁误诊困局:检验人如何让MYH9相关疾病无处遁形
作者:李福飞,淄博市妇幼保健院
前言
MYH9相关疾病(MYH9-RD)是一组由MYH9基因突变导致的常染色体 显性遗传性巨血小板减少症谱系,主要包括May-Hegglin异常(MHA)、Sebastian综合征(SBS)、Fechtner综合征(FTNS)和Epstein综合征(EPS)[1]。其共同特征是巨血小板减少症,但临床表现各异,部分伴有白细胞包涵体、感音神经性耳聋
显性遗传性巨血小板减少症谱系,主要包括May-Hegglin异常(MHA)、Sebastian综合征(SBS)、Fechtner综合征(FTNS)和Epstein综合征(EPS)[1]。其共同特征是巨血小板减少症,但临床表现各异,部分伴有白细胞包涵体、感音神经性耳聋 、肾炎或白内障
、肾炎或白内障 [2]。
[2]。
由于患者常表现为无症状或轻微出血的血小板减少,极易被误诊为原发免疫性血小板减少症 (ITP),导致不必要的糖皮质激素
(ITP),导致不必要的糖皮质激素 、免疫抑制剂甚至脾切除治疗[3]。因此,检验科在早期识别、精准诊断和鉴别诊断中扮演着决定性角色。
、免疫抑制剂甚至脾切除治疗[3]。因此,检验科在早期识别、精准诊断和鉴别诊断中扮演着决定性角色。
本文将从检验科实操角度,系统阐述MYH9-RD四种核心疾病的实验室检测特征、鉴别要点及流程优化建议。
01MYH9基因基础与检验诊断的重要性
MYH9基因位于染色体22q12-13,编码非肌性肌球蛋白重链IIA(NMMHC-IIA),该蛋白在血小板、粒细胞、肾脏、耳蜗及晶状体等多种组织中表达,参与细胞骨架构建、细胞分裂和运动[4]。
MYH9基因突变导致NMMHC-IIA功能异常,引起一系列临床表现重叠但各有侧重的疾病,即MHA、SBS、FTNS和EPS[5]。目前认为,这四种疾病是同一基因突变导致的不同表型谱,可统称为MYH9相关疾病(MYH9-RD)[6]。
检验科是发现此类疾病的第一道关口。患者常因“血小板减少”就诊,若仅依赖全自动血细胞分析仪 结果,极易误判为ITP。据统计,约60%的MYH9-RD患者曾被误诊为ITP,其中30%接受了不恰当的治疗[7]。
结果,极易误判为ITP。据统计,约60%的MYH9-RD患者曾被误诊为ITP,其中30%接受了不恰当的治疗[7]。
因此,检验人员对血常规 参数、外周血涂片
参数、外周血涂片 形态的敏锐观察,以及对特定检验项目(如白细胞包涵体检查、基因检测)的合理应用,是实现早期正确诊断、避免误诊误治的关键。
形态的敏锐观察,以及对特定检验项目(如白细胞包涵体检查、基因检测)的合理应用,是实现早期正确诊断、避免误诊误治的关键。
02四种MYH9相关疾病的检验相关解析
检验科对MYH9-RD的诊断核心在于“形态学”和“分子生物学”的结合。以下分述四种疾病的检验特征。
1. May-Hegglin异常(MHA)
MHA是MYH9-RD的经典类型,以“血小板减少、巨大血小板、中性粒细胞包涵体”三联征为特征[8]。
血常规与血小板参数:血小板计数(PLT)通常为轻度至中度减少。关键指标:平均血小板体积(MPV)和血小板分布宽度(PDW)显著增高。有研究显示,MHA患者的MPV和PDW明显高于ITP患者和正常对照组,是重要的鉴别要素[9]。
全自动血细胞分析仪(如采用阻抗法)可能因巨大血小板体积接近红细胞或淋巴细胞而低估实际PLT,导致“假性”血小板重度减少[10]。因此,当仪器报警提示“血小板异常直方图”及“血小板减少”时,必须进行血小板手工计数或外周血涂片复检。
外周血涂片形态学(核心诊断依据):
血小板形态:镜下可见大量直径>4µm的巨大血小板,甚至可达红细胞大小(见图1:绿色箭头所指)。这是提示遗传性巨血小板减少症的首要线索。
白细胞包涵体:经瑞特-姬姆萨(Wright-Giemsa)染色后,在中性粒细胞、嗜酸性粒细胞及单核细胞胞浆中可见清晰的、边界清楚的纺锤形或椭圆形嗜碱性包涵体,即典型的杜勒(Döhle)样小体(见图1:红色箭头所指)[11]。这些包涵体是NMMHC-IIA异常聚集形成的[12]。
检验实操要点:血涂片制备后应尽快染色(最好在4小时内),以保持包涵体着色清晰;阅片时需使用油镜(1000×)仔细扫描。
其他检验:血小板膜糖蛋白(如GPⅡb/Ⅲa、GPⅠb/Ⅸ)流式细胞术检测通常正常,可与Bernard-Soulier综合征等鉴别。确诊需进行MYH9基因测序,常见突变位点包括E1841K、R1933X等[13]。
2. Sebastian综合征(SBS)
SBS临床表现与MHA相似,但白细胞包涵体的超微结构不同。
检验特征:血常规和血小板形态改变与MHA类似,均有巨血小板减少。
核心鉴别点在于白细胞包涵体的形态:在瑞特-吉姆萨染色下,SBS的包涵体通常比MHA的更小、染色更淡、结构更不规则,且更多位于细胞边缘[14]。电镜下,MHA包涵体含有平行排列的高密度细丝,而SBS包涵体主要由成簇的核糖体和少量粗面内质网碎片组成,无平行细丝结构[15]。在常规检验中,仅凭光镜有时难以区分,需结合临床或基因检测。SBS通常不伴有肾炎、耳聋或白内障[16]。
3. Fechtner综合征(FTNS)
FTNS除具有巨血小板减少和白细胞包涵体外,还伴有Alport综合征 样表现(肾炎、感音神经性耳聋、白内障)[17]。
样表现(肾炎、感音神经性耳聋、白内障)[17]。
血液学检验:与MHA/SBS一致,表现为血小板减少伴巨大血小板。其白细胞包涵体在光镜下与SBS相似,多为小而圆的淡蓝色包涵体[18](见图2)。
关键鉴别检验——非血液系统指标:检验科应关注提示系统受累的指标。
基因型-表型关联:FTNS与特定MYH9突变相关,如R702C/H、D1424N等。有研究发现,R702位点突变与肾损害和耳聋的发生高度相关[19]。因此,对于疑似患者,检验科在报告血常规异常时,可提示临床关注尿常规 和肾功能。
和肾功能。
4. Epstein综合征(EPS)
EPS特征为巨血小板减少、肾炎和耳聋,但通常无白细胞包涵体[20]。
检验核心矛盾点:患者有典型的巨血小板减少,但瑞特-吉姆萨染色血涂片中常找不到明确的白细胞包涵体。这是其与MHA、SBS、FTNS鉴别的关键[21]。若临床高度怀疑,可采用中性粒细胞NMMHC-IIA免疫荧光检测作为筛查,该方法可显示NMMHC-IIA在胞浆内的异常聚集,即使光镜下未见包涵体也能发现异常,敏感度更高[22]。
系统受累检验:同FTNS,需进行尿蛋白、肾功能等检查以评估肾损害。
03四种疾病的检验鉴别要点及与ITP的鉴别
检验科在鉴别这四种疾病及排除ITP时,应构建以下实操流程:
1. MYH9-RD内部鉴别要点
(1)白细胞包涵体:是初步分型的核心。
MHA:大、清晰、纺锤形嗜碱性包涵体(中性粒细胞、嗜酸性粒细胞、单核细胞均有)。
SBS/FTNS:小、淡染、圆形或不规则包涵体(光镜下难区分)。
EPS:通常无包涵体(需免疫荧光确认)。
(2)血小板参数:四种疾病均有MPV、PDW显著增高,但无区分价值。
(3)系统受累指标:尿常规(尿蛋白、红细胞)和肾功能(肌酐、尿素氮) 是区分单纯血液型(MHA、SBS)与综合征型(FTNS、EPS)的关键检验项目。听力图 和眼科检查
和眼科检查 需临床完成,但检验科可基于尿液和肾功能异常结果,强烈提示FTNS或EPS的可能。
需临床完成,但检验科可基于尿液和肾功能异常结果,强烈提示FTNS或EPS的可能。
(4)基因检测:是最终确诊和精细化分型的金标准。建议对疑似患者进行MYH9基因全部40个外显子的扩增测序[23]。常见突变位点具有表型提示意义,如E1841K多见于MHA/FTNS[24],R702C/H与FTNS/EPS/APSM(Alport样综合征)相关且肾耳受累风险高[25],S96L突变也与严重表型相关[26]。
(5)MYH9相关疾病亚型鉴别要点(见表1)

2. MYH9相关疾病与免疫性血小板减少症(ITP)的检验鉴别
这是避免误诊的重中之重,鉴别要点如下(见表2):

检验科警示:当遇到“血小板减少伴MPV显著增高”的标本时,必须进行外周血涂片染色镜检。若发现巨大血小板比例高,应立即寻找白细胞包涵体,并询问临床医生是否有家族史。若同时存在包涵体,高度提示MYH9-RD(MHA/SBS/FTNS);若无包涵体但血小板巨大,且临床有肾/耳病史,应考虑EPS并建议免疫荧光或基因检测。绝不能仅凭“血小板减少”就默认为ITP。
04检验总结与临床衔接
1. 检验流程优化建议
(1)建立筛查流程:将“PLT减少伴MPV>12fl”或“血小板直方图右移/异常”设为触发规则,自动提示涂片染色镜检。
(2)规范镜检操作:制定血涂片寻找白细胞包涵体的标准化流程(染色时间、阅片范围),并对检验人员进行专项培训。
(3)项目组合推荐:对疑似患者,可推出“MYH9-RD筛查套餐”:全血细胞分析+外周血涂片染色镜检(含包涵体描述)+网织血小板比率(IPF,反映血小板生成,MYH9-RD通常不低)+尿常规。若筛查阳性,启动MYH9基因测序。
(4)应用辅助技术:有条件者可开展中性粒细胞NMMHC-IIA免疫荧光检测,作为高敏感度的筛查手段,尤其对EPS和包涵体不典型的病例[29]。
2. 检测结果的临床解读要点
检验报告不应只提供数据,应增加诊断性描述和提示:
(1)阳性发现报告:“镜下见大量巨大血小板及中性粒细胞胞浆内嗜碱性包涵体,符合遗传性巨血小板减少症形态学特征,建议排查MYH9相关疾病及家族史”。
(2)基因检测报告:除报告突变位点外,应备注常见基因型-表型关联,如“检出MYH9基因c.5521G>A (p.Glu1841Lys)突变,该突变常见于MHA或FTNS,建议临床评估听力、视力 及肾功能”。
及肾功能”。
(3)与临床沟通:主动告知MYH9-RD与ITP的治疗反应差异,强调避免不必要的免疫抑制治疗和脾切除。
3. 结合最新研究进展
(1)基因型-表型预测:最新研究进一步明确,突变位于NMMHC-IIA头部(如R702、S96)的患者发生终末期肾病和耳聋的风险高、时间早;而尾部突变(如E1841K、D1424N)患者多仅表现为血液系统异常,终身发生肾、耳并发症风险极低[30]。检验科在基因报告解读时可提供此信息,助力临床预后判断和随访管理。
(2)血小板功能新认知:研究提示MYH9-RD患者血小板收缩力可能受损,但常规聚集试验可能正常[31]。未来更精细的血小板功能评估可能纳入检验范畴。
总结
MYH9相关疾病是一组可通过检验手段早期精准识别的遗传性疾病。检验科工作人员是破解“不明原因血小板减少”谜题的关键角色。通过熟练掌握血常规参数解读、外周血涂片形态学观察(尤其是巨大血小板和白细胞包涵体),并合理运用尿检 、基因检测等工具,可以有效区分MHA、SBS、FTNS、EPS,并与最常见的ITP进行鉴别。建立系统化的检验筛查与诊断流程,提供具有临床指导意义的报告,能够从根本上避免误诊误治,引导患者接受正确的遗传咨询、并发症监测与管理,充分体现检验医学的临床价值。
、基因检测等工具,可以有效区分MHA、SBS、FTNS、EPS,并与最常见的ITP进行鉴别。建立系统化的检验筛查与诊断流程,提供具有临床指导意义的报告,能够从根本上避免误诊误治,引导患者接受正确的遗传咨询、并发症监测与管理,充分体现检验医学的临床价值。
专业审核:窦心灵 [ 上海市第一人民医院酒泉医院(酒泉市人民医院)]
参考文献略。
来源:检验医学网
